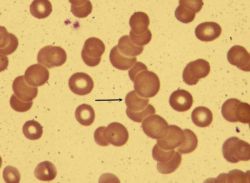
Скорость оседания эритроцитов повышена: возможные причины

Скорость оседания эритроцитов повышена: возможные причины
По результатам анализа крови обнаружилось, что у вас скорость оседания эритроцитов повышена? О том, на какие заболевания это может указывать, читайте в данной статье.
Татьяна Рудакова
По результатам анализа крови обнаружилось, что у вас скорость оседания эритроцитов повышена? О том, на какие заболевания это может указывать, читайте в данной статье.
Татьяна Рудакова
Средство «Компливит» инструкция определяет как комбинированный препарат, включающий в состав комплекс минералов и витаминов, необходимых для улучшения метаболических процессов. Разработано лекарство с целью восполнения в организме физиологически необходимых веществ.
Татьяна Рудакова
Основной причиной инвалидности и смертности во всем мире являются сердечно-сосудистые заболевания (ССЗ). Ни по какой другой причине не умирает ежегодно столько людей, сколько от проблем с сердцем. Опередив даже рак, ССЗ на сегодняшний день представляют настоящую угрозу человечеству.
Татьяна Рудакова
Почти все мы с детства знаем о таком средстве, как зеленка. Состав его, однако, знаком далеко не всем. Из чего и как делают это средство?
Татьяна Рудакова
Лекарство «Кларитин» инструкция по применению называет антигистаминным средством, блокатором Н1-рецепторов. Активным компонентом медикамента служит лоратадин, способный оказать длительное противоаллергическое действие.
Татьяна Рудакова
Лекарственное средство «Тималин» является препаратом, обладающим иммуностимулирующими свойствами. Инструкция по применению указывает, что использование средства позволяет восстановить у человека иммунологическую активность, другими словами, способствует повышению защиты организма от болезнетворных микроорганизмов.
Татьяна Рудакова
Лекарство «Флуконазол» относится к препаратам, которые обладают противогрибковым эффектом. Инструкция указывает, что работа медикамента заключается в замедлении активности ферментов грибов.
Татьяна Рудакова
Лекарство «Эриус» является противоаллергическим препаратом, блокатором гистаминовых рецепторов. Медикамент производится в форме таблеток голубого цвета, а также прозрачного оранжевого сиропа.
Татьяна Рудакова
Одним из самых важных для жизни человека органов является печень. Она – мощный природный очиститель организма от токсических веществ, продуктов распада, гормонов и химических соединений. При этом функции печени в организме человека не ограничиваются только этим. Они крайне разнообразны, основные из них следующие...
Татьяна Рудакова
Современная промышленность использует уникальное дерево при производстве разнообразных лекарственных средств. Это становится возможным благодаря наличию в коре этого целебного дерева большого количества дубильных веществ. Отвар, приготовленный из уникального сырья, нередко находит свое применение в косметических салонах.
Татьяна Рудакова